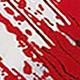

Products

-
1 Adult Latex Dog Head Shaped Funny Personalized Costume Mask Halloween 1 Adult Latex Dog Head Shaped Funny Personalized Costume Mask Halloween
$19.991 Adult Latex Dog Head Shaped Funny Personalized Costume Mask Halloween
$19.99 -
1 Pack Childproof Door Knob Covers Babyproof Child Door Locks Door Handle Baby Proofing Door Safety For Kids 1 Pack Childproof Door Knob Covers Babyproof Child Door Locks Door Handle Baby Proofing Door Safety For Kids
$5.991 Pack Childproof Door Knob Covers Babyproof Child Door Locks Door Handle Baby Proofing Door Safety For Kids
$5.99 -
1 Pair Of Multi-Color Cosplay Elf Ears Decoration, Halloween Party Dress Props Latex Elf Pointed Ears Toy, Halloween Party Gifts, Halloween Party Decoration Props, Photo Props, Atmosphere Creation Supplies, Photo Props, Suitable For Party, Carnival, Fest 1 Pair Of Multi-Color Cosplay Elf Ears Decoration, Halloween Party Dress Props Latex Elf Pointed Ears Toy, Halloween Party Gifts, Halloween Party Decoration Props, Photo Props, Atmosphere Creation Supplies, Photo Props, Suitable For Party, Carnival, Fest
$4.991 Pair Of Multi-Color Cosplay Elf Ears Decoration, Halloween Party Dress Props Latex Elf Pointed Ears Toy, Halloween Party Gifts, Halloween Party Decoration Props, Photo Props, Atmosphere Creation Supplies, Photo Props, Suitable For Party, Carnival, Fest
$4.99 -
1 Pair Of Outdoor Hiking 5/8-Tooth Ice Claw Anti Slip Shoe Covers Suitable For Snow Boots, Lightweight Ice Grip For Men And Women, Durable Steel Nails For Elderly People, Hiking, And Ice Walking To Maintain 1 Pair Of Outdoor Hiking 5/8-Tooth Ice Claw Anti Slip Shoe Covers Suitable For Snow Boots, Lightweight Ice Grip For Men And Women, Durable Steel Nails For Elderly People, Hiking, And Ice Walking To Maintain
$4.991 Pair Of Outdoor Hiking 5/8-Tooth Ice Claw Anti Slip Shoe Covers Suitable For Snow Boots, Lightweight Ice Grip For Men And Women, Durable Steel Nails For Elderly People, Hiking, And Ice Walking To Maintain
$4.99 -
1 Piece 3L Water Bag Backpack Water Bag Bag Cycling Outdoor Hiking Camping Bag 1 Piece 3L Water Bag Backpack Water Bag Bag Cycling Outdoor Hiking Camping Bag
$15.991 Piece 3L Water Bag Backpack Water Bag Bag Cycling Outdoor Hiking Camping Bag
$15.99 -
1 Set (12 Knives) - Halloween Wreath Banner Prop, Haunted House Knife Hanging Decoration, Halloween Decoration, Halloween Zombie Vampire Party Decoration, Haunted House Bar Supplies, Office Home Indoor And Outdoor Courtyard Decoration, Weapon Hanging Ban 1 Set (12 Knives) - Halloween Wreath Banner Prop, Haunted House Knife Hanging Decoration, Halloween Decoration, Halloween Zombie Vampire Party Decoration, Haunted House Bar Supplies, Office Home Indoor And Outdoor Courtyard Decoration, Weapon Hanging Ban
$14.991 Set (12 Knives) - Halloween Wreath Banner Prop, Haunted House Knife Hanging Decoration, Halloween Decoration, Halloween Zombie Vampire Party Decoration, Haunted House Bar Supplies, Office Home Indoor And Outdoor Courtyard Decoration, Weapon Hanging Ban
$14.99 -
1 Set of Advanced Resistance Belt with Handle Heavy Sports Belt for Strength Training Home Gym and Fitness Exercise 1 Set of Advanced Resistance Belt with Handle Heavy Sports Belt for Strength Training Home Gym and Fitness Exercise
$0.001 Set of Advanced Resistance Belt with Handle Heavy Sports Belt for Strength Training Home Gym and Fitness Exercise
$0.00 -
1/10pcs Halloween Party Drink Bags Vampire Blood Bags Transparent Reusable And Refillable With Labels And Clips For Party Drinks And Costume Accessories Great For Halloween Party, Halloween Decorations, Happy Halloween 1/10pcs Halloween Party Drink Bags Vampire Blood Bags Transparent Reusable And Refillable With Labels And Clips For Party Drinks And Costume Accessories Great For Halloween Party, Halloween Decorations, Happy Halloween
$4.991/10pcs Halloween Party Drink Bags Vampire Blood Bags Transparent Reusable And Refillable With Labels And Clips For Party Drinks And Costume Accessories Great For Halloween Party, Halloween Decorations, Happy Halloween
$4.99 -
1/2pcs Door Stopper, Punch-Free Rubber Door Stopper, Child-Proof, Overlappable, Gray, Transparent, Silicone Door Stopper, Anti-Collision, Windproof Door Stopper 1/2pcs Door Stopper, Punch-Free Rubber Door Stopper, Child-Proof, Overlappable, Gray, Transparent, Silicone Door Stopper, Anti-Collision, Windproof Door Stopper
$1.481/2pcs Door Stopper, Punch-Free Rubber Door Stopper, Child-Proof, Overlappable, Gray, Transparent, Silicone Door Stopper, Anti-Collision, Windproof Door Stopper
$1.48 -
1/3/5Pcs Halloween Black Crow Model Simulation Fake Bird Animal Scary Toys For Halloween Party Home Decoration Horror Props Fall Autumn,Christmas 1/3/5Pcs Halloween Black Crow Model Simulation Fake Bird Animal Scary Toys For Halloween Party Home Decoration Horror Props Fall Autumn,Christmas
$4.991/3/5Pcs Halloween Black Crow Model Simulation Fake Bird Animal Scary Toys For Halloween Party Home Decoration Horror Props Fall Autumn,Christmas
$4.99 -
1/3/5Pcs Set Cyberpunk Robotic Arm Hand Game Controller Stand Support Statue Holder For Phone Gamepad Headset Mount Rack 1/3/5Pcs Set Cyberpunk Robotic Arm Hand Game Controller Stand Support Statue Holder For Phone Gamepad Headset Mount Rack
Regular price $27.61 Sale price $14.991/3/5Pcs Set Cyberpunk Robotic Arm Hand Game Controller Stand Support Statue Holder For Phone Gamepad Headset Mount Rack
Sale price $14.99 Regular price $27.61 -
10 Pairs Girls Cartoon Animal Socks, Soft & Comfortable, Cute Bear/Butterfly/Rabbit Designs, Fashionable Daily/Holiday Gift/Travel Wear, Assorted Colors & Styles 10 Pairs Girls Cartoon Animal Socks, Soft & Comfortable, Cute Bear/Butterfly/Rabbit Designs, Fashionable Daily/Holiday Gift/Travel Wear, Assorted Colors & Styles
$5.9910 Pairs Girls Cartoon Animal Socks, Soft & Comfortable, Cute Bear/Butterfly/Rabbit Designs, Fashionable Daily/Holiday Gift/Travel Wear, Assorted Colors & Styles
$5.99 -
10-Person Cabin Tent, With 3 Entrances -
1000000LM Most Powerful LED Flashlight Rechargeable Type-C Flashlight Long Range 6000M Tactical Torch Light For Fishing Hunting 1000000LM Most Powerful LED Flashlight Rechargeable Type-C Flashlight Long Range 6000M Tactical Torch Light For Fishing Hunting
$19.991000000LM Most Powerful LED Flashlight Rechargeable Type-C Flashlight Long Range 6000M Tactical Torch Light For Fishing Hunting
$19.99 -
100pcs Black Industrial Self-Locking High-Strength Nylon Cable Ties 100pcs Black Industrial Self-Locking High-Strength Nylon Cable Ties
$9.99100pcs Black Industrial Self-Locking High-Strength Nylon Cable Ties
$9.99 -
10m Length 7-Core Reflective Umbrella Cord, 4mm Diameter, Night-Reflecting Outdoor Tent Rope, Handmade Bracelet Braided Cord, Clothesline, Outdoor Emergency Rope Camping Camping Stuff 10m Length 7-Core Reflective Umbrella Cord, 4mm Diameter, Night-Reflecting Outdoor Tent Rope, Handmade Bracelet Braided Cord, Clothesline, Outdoor Emergency Rope Camping Camping Stuff
$5.9910m Length 7-Core Reflective Umbrella Cord, 4mm Diameter, Night-Reflecting Outdoor Tent Rope, Handmade Bracelet Braided Cord, Clothesline, Outdoor Emergency Rope Camping Camping Stuff
$5.99 -
10pcs Carbon Steel Fishing Hook -
10pcs Cartoon Style False Eyelashes, One Piece Eyelash Extensions With Transparent Natural Look, Dense & Curly Design, Suitable For Beginners, Reusable 10pcs Cartoon Style False Eyelashes, One Piece Eyelash Extensions With Transparent Natural Look, Dense & Curly Design, Suitable For Beginners, Reusable
$5.0010pcs Cartoon Style False Eyelashes, One Piece Eyelash Extensions With Transparent Natural Look, Dense & Curly Design, Suitable For Beginners, Reusable
$5.00 -
10pcs/Pack Men's Comfy Solid Color Long Boxer Briefs - Quick Dry, Durable, Breathable, Stretchy, Loose Fit - Suitable For All Seasons, Workouts, Beach, Pool And Daily Wear 10pcs/Pack Men's Comfy Solid Color Long Boxer Briefs - Quick Dry, Durable, Breathable, Stretchy, Loose Fit - Suitable For All Seasons, Workouts, Beach, Pool And Daily Wear
Regular price $28.14 Sale price $19.9910pcs/Pack Men's Comfy Solid Color Long Boxer Briefs - Quick Dry, Durable, Breathable, Stretchy, Loose Fit - Suitable For All Seasons, Workouts, Beach, Pool And Daily Wear
Sale price $19.99 Regular price $28.14 -
11pcs Halloween Bloody Handprints And Footprints Window Stickers, Wall Stickers, Suitable For Halloween Party Decorations, Indoor And Outdoor Decorations, Halloween Background Decorations, Horror Theme Party Decorations 11pcs Halloween Bloody Handprints And Footprints Window Stickers, Wall Stickers, Suitable For Halloween Party Decorations, Indoor And Outdoor Decorations, Halloween Background Decorations, Horror Theme Party Decorations
$10.0011pcs Halloween Bloody Handprints And Footprints Window Stickers, Wall Stickers, Suitable For Halloween Party Decorations, Indoor And Outdoor Decorations, Halloween Background Decorations, Horror Theme Party Decorations
$10.00 -
12pcs Baby Safety Cabinet Locks, Child Proof Drawer Locks, Adjustable No Drill Cabinet Locks With Straps, Suitable For Child Safety Drawers, Ensure Child Safety 12pcs Baby Safety Cabinet Locks, Child Proof Drawer Locks, Adjustable No Drill Cabinet Locks With Straps, Suitable For Child Safety Drawers, Ensure Child Safety
$4.9912pcs Baby Safety Cabinet Locks, Child Proof Drawer Locks, Adjustable No Drill Cabinet Locks With Straps, Suitable For Child Safety Drawers, Ensure Child Safety
$4.99 -
13pcs Dumpling Maker Set With Wooden Handles - Versatile Ravioli, Lasagna, And Pierogi Cutter Tools, Includes Stamp Makers, Circular Dumplings Molds, And Pastry Spoons - Ideal For Homemade Pasta And Pierogi 13pcs Dumpling Maker Set With Wooden Handles - Versatile Ravioli, Lasagna, And Pierogi Cutter Tools, Includes Stamp Makers, Circular Dumplings Molds, And Pastry Spoons - Ideal For Homemade Pasta And Pierogi
$15.9913pcs Dumpling Maker Set With Wooden Handles - Versatile Ravioli, Lasagna, And Pierogi Cutter Tools, Includes Stamp Makers, Circular Dumplings Molds, And Pastry Spoons - Ideal For Homemade Pasta And Pierogi
$15.99 -
15/50Pcs Deep Cleansing Nose Stickers, Nose Spot Facial Stickers, Nose Mask, Nose Mask For Cleaning Acne Blackheads 15/50Pcs Deep Cleansing Nose Stickers, Nose Spot Facial Stickers, Nose Mask, Nose Mask For Cleaning Acne Blackheads
$9.9915/50Pcs Deep Cleansing Nose Stickers, Nose Spot Facial Stickers, Nose Mask, Nose Mask For Cleaning Acne Blackheads
$9.99 -
152.4cm Full Size Inflatable Body Mannequin DIY Halloween Decorations Cosplay Props Inflatable Dummy Perfect To Dress Up &Costume, Christmas, Halloween, Thanksgiving Day Gift Halloween Gift 152.4cm Full Size Inflatable Body Mannequin DIY Halloween Decorations Cosplay Props Inflatable Dummy Perfect To Dress Up &Costume, Christmas, Halloween, Thanksgiving Day Gift Halloween Gift
$19.99152.4cm Full Size Inflatable Body Mannequin DIY Halloween Decorations Cosplay Props Inflatable Dummy Perfect To Dress Up &Costume, Christmas, Halloween, Thanksgiving Day Gift Halloween Gift
$19.99